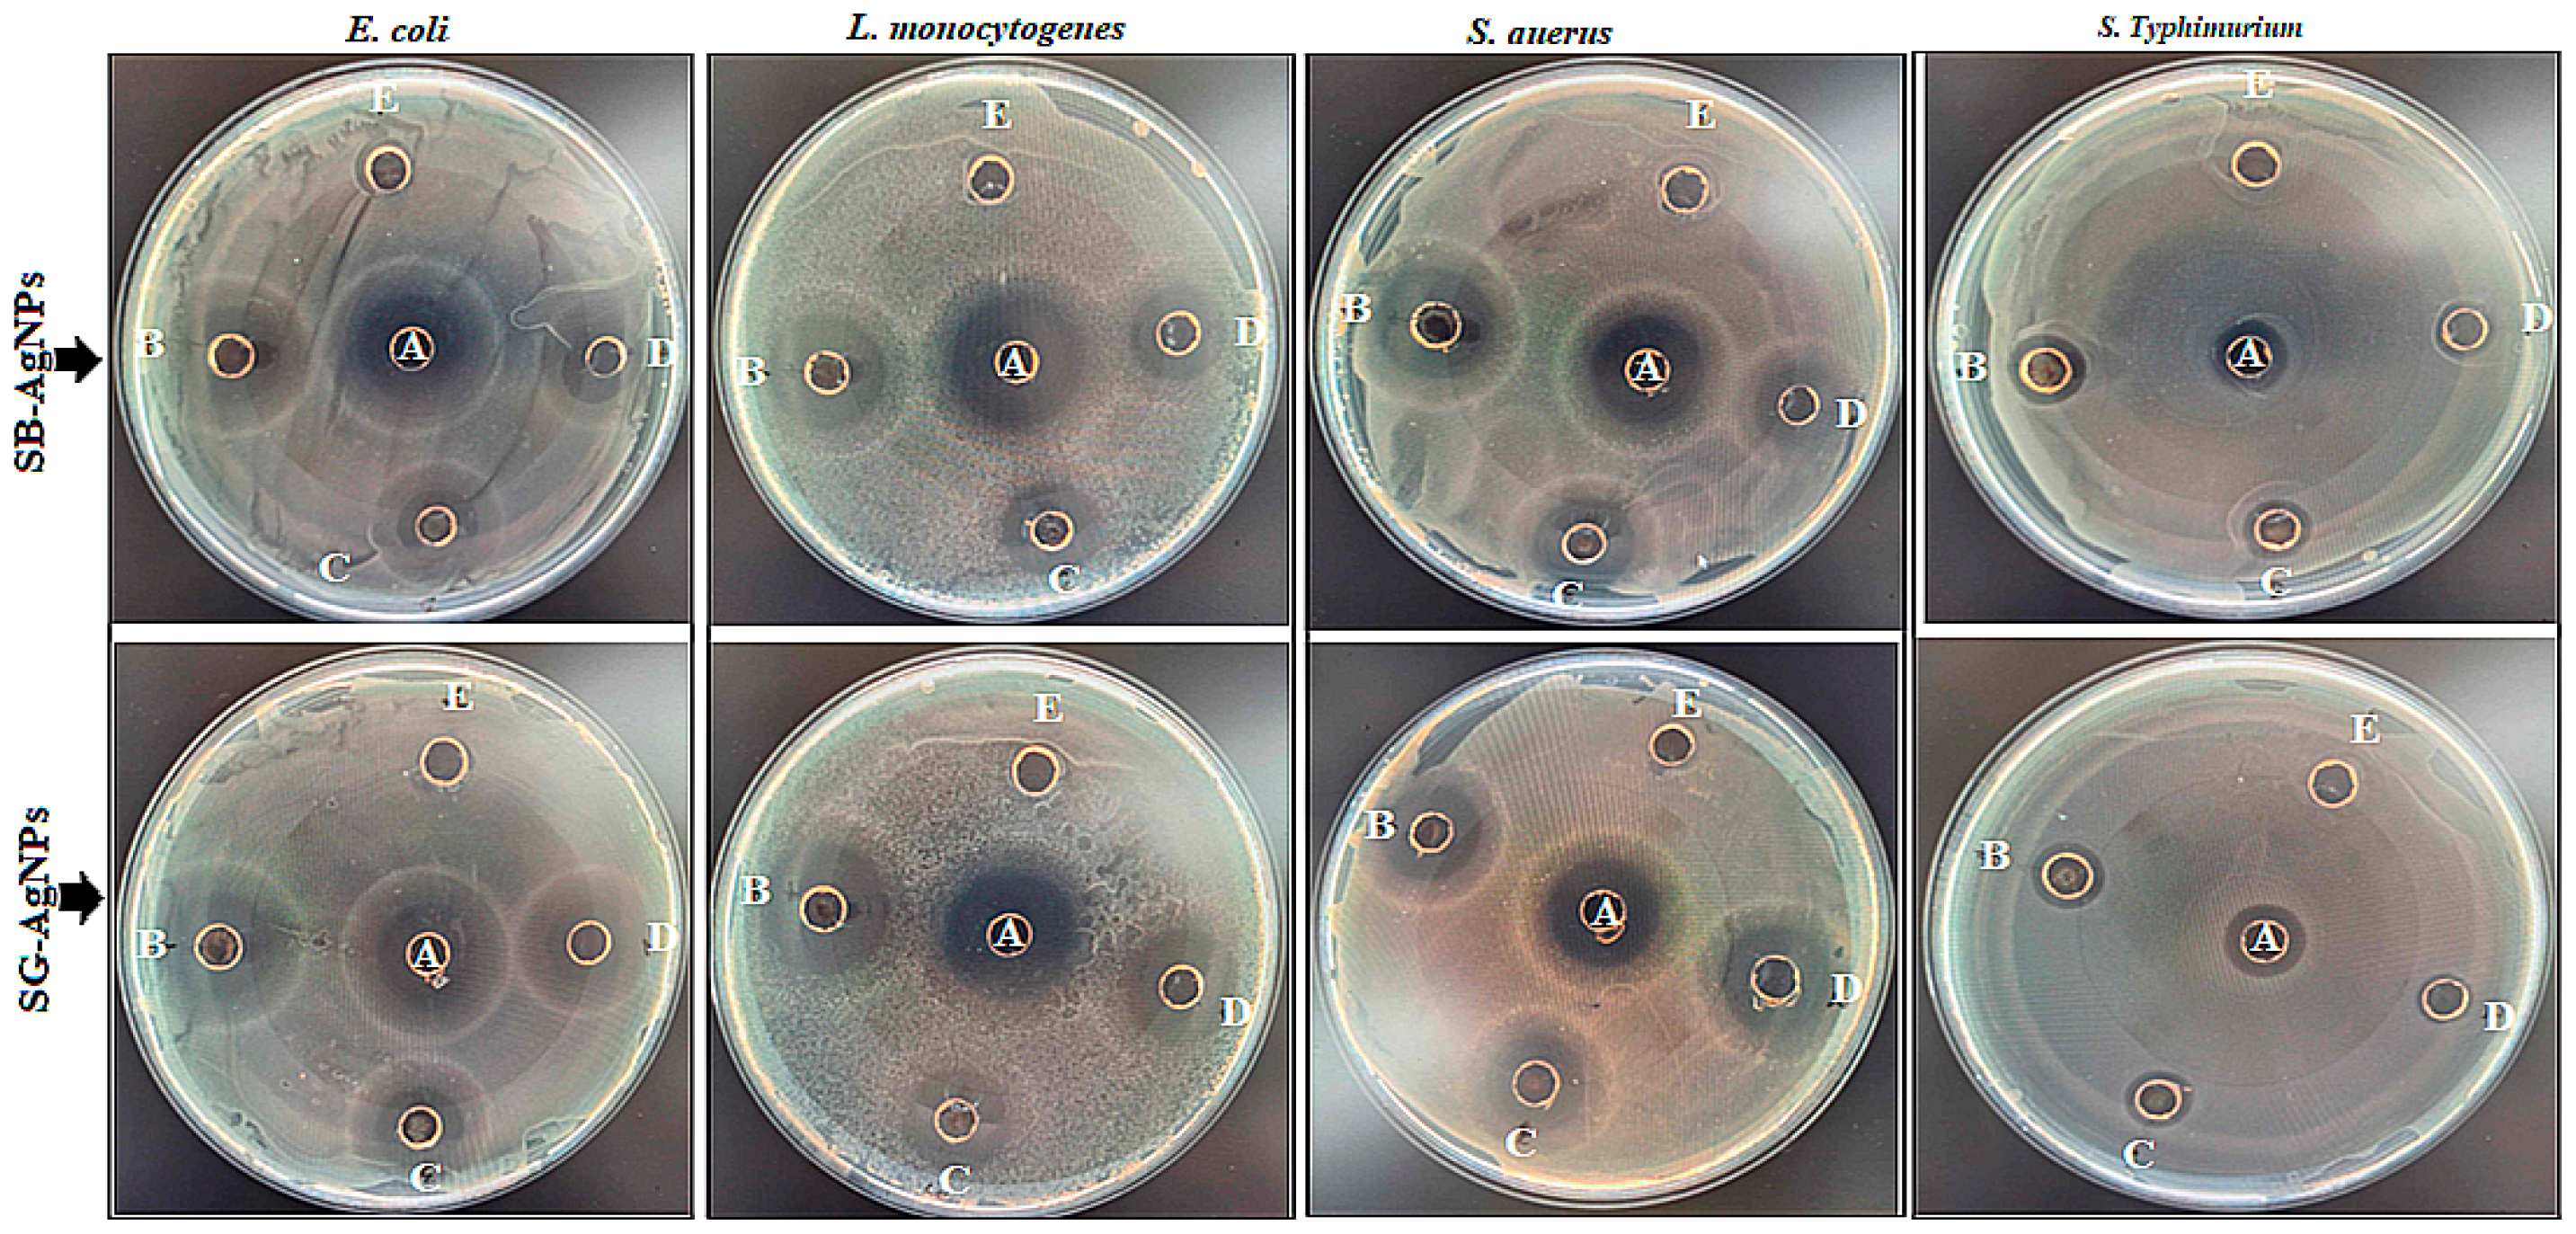
Ijms 25 00904 g008

Green Synthesis of Novel Silver Nanoparticles Using Salvia blepharophylla and Salvia greggii: Antioxidant and Antidiabetic Potential and Effect on Foodborne Bacterial Pathogens
Abstract
1. Introduction
2. Results and Discussion
2.1. Nanoparticle Synthesis and Characterization
2.2. Antibacterial Effects of Biosynthesized AgNPs on Foodborne Pathogens
2.3. Antioxidant Activity of SB-AgNPs and SG-AgNPs
2.4. Antidiabetic Activities of SB-AgNPs and SG-AgNPs
3. Materials and Methods
3.1. Plant Samples and Chemicals
3.2. Preparation of Plant Extracts
3.3. Green Synthesis of Silver Nanoparticles
3.4. Characterization of SB-AgNPs and SG-AgNPs
3.5. Antibacterial Activity
3.5.1. Sensitivity Test
3.5.2. Minimum Inhibitory and Minimum Bactericidal Concentrations of SB-AgNPs and SG-AgNPs
3.6. Evaluation of Antioxidant Assay
3.7. Antidiabetic Activities of SB-AgNPs and SG-AgNPs
3.8. Statistical Analysis
4. Conclusions
Author Contributions
Funding
Institutional Review Board Statement
Informed Consent Statement
Data Availability Statement
Acknowledgments
Conflicts of Interest
References
- WHO. WHO Estimates the Global Burden of Foodborne Diseases: Foodborne Disease Burden Epidemiology Reference Group 2007–2015. 2015. Available online: https://reliefweb.int/sites/reliefweb.int/files/resources/WHO%20estimates%20of%20the%20global%20foodborne%20diseases%20FINAL.pdf (accessed on 1 December 2015).
- Pires, S.M.; Desta, B.N.; Mughini-Gras, L.; Mmbaga, B.T.; Fayemi, O.E.; Salvador, E.M.; Gobena, T.; Majowicz, S.E.; Hald, T.; Hoejskov, P.S.; et al. Burden of Foodborne Diseases: Think Global, Act Local. Curr. Opin. Food Sci. 2021, 39, 152–159. [Google Scholar] [CrossRef]
- Zorraquín-Peña, I.; Cueva, C.; Bartolomé, B.; Moreno-Arribas, M.V. Silver Nanoparticles against Foodborne Bacteria. Effects at Intestinal Level and Health Limitations. Microorganisms 2020, 8, 132. [Google Scholar] [CrossRef]
- D’Ostuni, V.; Tristezza, M.; De Giorgi, M.G.; Rampino, P.; Grieco, F.; Perrotta, C. Occurrence of Listeria monocytogenes and Salmonella spp. in Meat Processed Products from Industrial Plants in Southern Italy. Food Control. 2016, 62, 104–109. [Google Scholar] [CrossRef]
- Välimaa, A.L.; Tilsala-Timisjärvi, A.; Virtanen, E. Rapid detection and identification methods for Listeria monocytogenes in the food chain—A review. Food Control. 2015, 55, 103–114. [Google Scholar] [CrossRef]
- Heiman, K.E.; Mody, R.K.; Johnson, S.D.; Griffin, P.M.; Gould, L.H. Escherichia coli O157 outbreaks in the United States, 2003–2012. Emerg. Infect. Dis. 2015, 21, 1293–1301. [Google Scholar] [CrossRef]
- Biswas, S.; Niu, M.; Appuhamy, J.A.D.R.N.; Leytem, A.B.; Dungan, R.S.; Kebreab, E.; Pandey, P. Impacts of dietary forage and crude protein levels on the shedding of Escherichia coli O157:H7 and Listeria in dairy cattle feces. Livest. Sci. 2016, 194, 17–22. [Google Scholar] [CrossRef]
- Zhang, Y.; Yan, C.; Yang, H.; Yu, J.; Wei, H. Rapid and selective detection of E. coli O157:H7 combining phagomagnetic separation with enzymatic colorimetry. Food Chem. 2017, 234, 332–338. [Google Scholar] [CrossRef]
- Chen, J.-Q.; Regan, P.; Laksanalamai, P.; Healey, S.; Hu, Z. Prevalence and methodologies for detection, characterization and subtyping of Listeria monocytogenes and L. ivanovii in foods and environmental sources. Food Sci. Hum. Wellness 2017, 6, 97–120. [Google Scholar] [CrossRef]
- Tanwar, J.; Das, S.; Fatima, Z.; Hameed, S. Multidrug resistance: An emerging crisis. Interdiscip. Perspect. Infect. Dis. 2014, 2014, 541340. [Google Scholar] [CrossRef]
- Patel, G.; Huprikar, S.; Factor, S.H.; Jenkins, S.G.; Calfee, D.P. Outcomes of carbapenem-resistant Klebsiella pneumoniae infection and the impact of antimicrobial and adjunctive therapies. Infect. Control. Hosp. Epidemiol. 2008, 29, 1099–1106. [Google Scholar] [CrossRef]
- Alahmad, A.; Al-Zereini, W.A.; Hijazin, T.J.; Al-Madanat, O.Y.; Alghoraibi, I.; Al-Qaralleh, O.; Al-Qaraleh, S.; Feldhoff, A.; Walter, J.-G.; Scheper, T. Green Synthesis of Silver Nanoparticles Using Hypericum perforatum L. Aqueous Extract with the Evaluation of Its Antibacterial Activity against Clinical and Food Pathogens. Pharmaceutics 2022, 14, 1104. [Google Scholar] [CrossRef]
- Ikram, M.; Javed, B.; Raja, N.I.; Mashwani, Z.U.R. Biomedical Potential of Plant-based Selenium Nanoparticles: A Comprehensive Review on Therapeutic and Mechanistic Aspects. Int. J. Nanomed. 2021, 16, 249–268. [Google Scholar] [CrossRef]
- Bruna, T.; Maldonado-Bravo, F.; Jara, P.; Caro, N. Silver Nanoparticles and Their Antibacterial Applications. Int. J. Mol. Sci. 2021, 22, 7202. [Google Scholar] [CrossRef]
- Choi, I.; Yoo, D.S.; Chang, Y.; Kim, S.Y.; Han, J. Polycaprolactone film functionalized with bacteriophage T4 promotes antibacterial activity of food packaging toward Escherichia coli. Food Chem. 2021, 346, 128883. [Google Scholar] [CrossRef]
- Kumar, P.V.; Kala, S.M.J.; Prakash, K.S. Green synthesis of gold nanoparticles using Croton caudatus Geisel leaf extract and their biological studies. Mater Lett 2019, 236, 19–22. [Google Scholar] [CrossRef]
- Geremew, A.; Carson, L.; Woldesenbet, S. Biosynthesis of Silver Nanoparticles using Extract of Rumex nepalensis for Bactericidal Effect against Food-borne Pathogens and Antioxidant Activity. Front. Mol. Biosci. 2022, 9, 991669. [Google Scholar] [CrossRef]
- Prabhu, S.; Poulose, E.K. Silver Nanoparticles: Mechanism of Antimicrobial Action, Synthesis, Medical Applications, and Toxicity Effects. Int. Nano Lett. 2012, 2, 32. [Google Scholar] [CrossRef]
- Yin, I.X.; Zhang, J.; Zhao, I.S.; Mei, M.L.; Li, Q.; Chu, C.H. The antibacterial mechanism of silver nanoparticles and its application in dentistry. Int. J. Nanomed. 2020, 15, 2555–2562. [Google Scholar] [CrossRef]
- Soto, K.M.; Quezada-Cervantes, C.T.; Hernández-Iturriaga, M.; Luna-Bárcenas, G.; Vazquez-Duhalt, R.; Mendoza, S. Fruit Peels Waste for the Green Synthesis of Silver Nanoparticles with Antimicrobial Activity Against Foodborne Pathogens. LWT-Food Sci. Technol 2019, 103, 293–300. [Google Scholar] [CrossRef]
- Gecer, E.N. Green Synthesis of Silver Nanoparticles from Salvia aethiopis L. and Their Antioxidant Activity. J. Inorg. Organomet. Polym. Mater. 2021, 31, 4402–4409. [Google Scholar] [CrossRef]
- Li, H.; Song, C.; Liu, D.; Ai, Q.; Yu, J. Molecular Analysis of Biofilms on the Surface of Neonatal Endotracheal tubes based on 16S rRNA PCR-DGGE and Species-specific PCR. Int. J. Clin. Exp. Med. 2015, 8, 11075–11084. [Google Scholar]
- Zou, L.; Zhu, F.; Long, Z.; Huang, Y. Bacterial Extracellular Electron transfer: A Powerful route to the Green biosynthesis of Inorganic nanomaterials for Multifunctional Applications. J. Nanobiotechnology 2021, 19, 120. [Google Scholar] [CrossRef]
- Jini, D.; Sharmila, S. Green Synthesis of Silver Nanoparticles from Allium cepa and its In vitro Antidiabetic Activity. Mater. Today Proc. 2020, 22, 432–438. [Google Scholar] [CrossRef]
- Bedlovičová, Z.; Strapáč, I.; Baláž, M.; Salayová, A. A Brief Overview on Antioxidant Activity Determination of Silver Nanoparticles. Molecules 2020, 25, 3191. [Google Scholar] [CrossRef]
- Rajaram, K.; Aiswarya, D.C.; Sureshkumar, P. Green synthesis of silver nanoparticle using Tephrosia tinctoria and its antidiabetic activity. Mater. Lett. 2015, 138, 251–254. [Google Scholar] [CrossRef]
- Johnson, M.A.; Shibila, T.; Amutha, S.; Menezes, I.R.A.; da Costa, J.G.M.; Sampaio, N.F.L.; Coutinho, H.D.M. Synthesis of Silver Nanoparticles Using Odontosoria chinensis (L.) J. Sm. and Evaluation of their Biological Potentials. Pharmaceuticals 2020, 13, 66. [Google Scholar] [CrossRef]
- Pirtarighat, S.; Ghannadnia, M.; Baghshahi, S. Green Synthesis of Silver Nanoparticles using the Plant Extract of Salvia spinosa Grown in vitro and their Antibacterial Activity Assessment. J. Nanostruct. Chem. 2019, 9, 1–9. [Google Scholar] [CrossRef]
- Hernandez-Morales, L.; Espinoza-Gomez, H.; Flores-Lopez, L.Z.; Sotelo-Barrera, E.L.; Nunez-Rivera, A.; Cadena-Nava, R.D.; Alonso-Nunez, G.; Espinoza, K.A. Study of the Green Synthesis of Silver Nanoparticles using a Natural Extract of Dark or White Salvia hispanica L. Seeds and their Antibacterial Application. Appl. Surf. Sci. 2019, 489, 952–961. [Google Scholar] [CrossRef]
- Abaza, I.; Aboalhaija, N.; Alsalman, A.; Talib, W.; Afifi, F. Aroma Profile, Chemical Composition and Antiproliferative Activity of the Hydrodistilled Essential Oil of a Rare Salvia Species (Salvia greggii). J. Biologically Act. Prod. Nat. 2021, 11, 129–137. [Google Scholar] [CrossRef]
- Pereira, O.R.; Catarino, M.D.; Afonso, A.F.; Silva, A.M.S.; Cardoso, S.M. Salvia elegans, Salvia greggii and Salvia officinalis Decoctions: Antioxidant Activities and Inhibition of Carbohydrate and Lipid Metabolic Enzymes. Molecules 2018, 23, 3169. [Google Scholar] [CrossRef]
- Mihailovic, V.; Sreckovic, N.; Nedic, Z.P.; Dimitrijevic, S.; Matic, M.; Obradovic, A.; Selakovic, D.; Rosic, G.; Stankovic, K.J.S. Green Synthesis of Silver Nanoparticles Using Salvia verticillate and Filipendula ulmaria Extracts: Optimization of Synthesis, Biological Activities, and Catalytic Properties. Molecules 2023, 28, 808. [Google Scholar] [CrossRef]
- Takcl, D.K.; Ozdenefe, M.S.; Genc, S. Green synthesis of silver nanoparticles with an antibacterial activity using Salvia officinalis aqueous extract. J. Cryst. Growth 2023, 614, 127239. [Google Scholar]
- Sreckovic, N.Z.; Nedic, Z.P.; Monti, D.M.; D’Elia, L.; Dimitrijevic, S.B.; Mihailovic, N.R.; Stanković, J.S.K.; Mihailović, V.B. Biosynthesis of Silver Nanoparticles Using Salvia pratensis L. Aerial Part and Root Extracts: Bioactivity, Biocompatibility, and Catalytic Potential. Molecules 2023, 28, 1387. [Google Scholar] [CrossRef]
- Dube, P.; Meyer, S.; Madiehe, A.; Meyer, M. Antibacterial activity of biogenic silver and gold nanoparticles synthesized from Salvia africana-lutea and Sutherlandia frutescens. Nanotechnology 2020, 31, 15–505607. [Google Scholar] [CrossRef]
- Sharifi, F.; Sharififar, F.; Soltanian, S.; Doostmohammadi, M.; Mohamadi, N. Synthesis of silver nanoparticles using Salvia officinalis extract: Structural characterization, cytotoxicity, antileishmanial and antimicrobial activity. Nanomed. Res. J. 2020, 5, 339–346. [Google Scholar]
- Nicolescu, C.M.; Olteanu, R.L.; Bumbac, M. Growth Dynamics Study of Silver Nanoparticles Obtained by Green Synthesis using Salvia officinalis Extract. Anal. Lett. 2017, 50, 2802–2821. [Google Scholar] [CrossRef]
- Metwally, D.M.; Alajmi, R.A.; El-Khadragy, M.F.; Al-Quraishy, S. Silver Nanoparticles Biosynthesized with Salvia Officinalis leaf exert protective effect on hepatic tissue injury induced by Plasmodium Chabaudi. Front. Vet. Sci. 2021, 7, 620665. [Google Scholar] [CrossRef]
- Okaiyeto, K.; Hoppe, H.; Anthony, O.I. Plant-based synthesis of silver nanoparticles using aqueous leaf extract of Salvia Officinalis: Characterization and its antiplasmodial activity. J. Clust. Sci. 2021, 32, 101–109. [Google Scholar] [CrossRef]
- Albeladi, S.S.R.; Malik, M.A.; Al-thabaiti, S.A. Facile biofabrication of silver nanoparticles using Salvia officinalis leaf extract and its catalytic activity towards Congo red dye degradation. J. Mater. Res. Technol. 2020, 9, 10031–10044. [Google Scholar] [CrossRef]
- Pratik, R.; Shalaka, A.C.; Vrishali, B.M.; Kamble, P.S. Effect of biosynthesized silver nanoparticles on Staphylococcus aureus biofilm quenching and prevention of biofilm formation. Int. J. Pharm. Biosci. 2012, 3, 34–39. [Google Scholar]
- Vigneshwaran, N.; Nachane, R.P.; Balasubramanya, R.H.; Varadarajan, P.V. A novel one-pot ‘green’ synthesis of stable silver nanoparticles using soluble starch. Carbohydr. Res. 2007, 342, 2012–2018. [Google Scholar] [CrossRef]
- Ansar, S.; Tabassum, H.; Aladwan, N.S.M.; Ali, N.M.; Almaarik, B.; AlMahrouqi, S.; Abudawood, M.; Banu, N.; Alsubki, R. Ecofriendly silver nanoparticles synthesis by Brassica oleracea and its antibacterial, anticancer and antioxidant properties. Sci. Rep. 2020, 10, 18564. [Google Scholar] [CrossRef]
- Yousaf, H.; Ansar, M.; Khawaja, S.A.; Muhammad, R. Green synthesis of silver nanoparticles and their application as an alternative antibacterial and antioxidant agent. Mater. Sci. Eng. C 2020, 112, 110901. [Google Scholar] [CrossRef]
- Sharifi-Rad, M.; Pohl, P.; Epifano, F. Phytofabrication of Silver Nanoparticles (AgNPs) with Pharmaceutical Capabilities Using Otostegia persica (Burm.) Boiss. Leaf Extract. Nanomaterials 2021, 11, 1045. [Google Scholar] [CrossRef]
- Saranyadevi, S. Multifaceted targeting strategies in cancer against the human notch 3 protein: A computational study. Silico Pharmacology 2021, 9, 53. [Google Scholar] [CrossRef]
- Paramelle, D.; Sadovoy, A.; Gorelik, S.; Free, P.; Hobley, J.; Fernig, D.G. A rapid method to estimate the concentration of citrate capped silver nanoparticles from UV-Visible light spectra. Analyst 2014, 139, 4855–4861. [Google Scholar] [CrossRef]
- Lopes, L.C.S.; Brito, L.M.; Bezerra, T.T.; Gomes, K.N.; De, F.A.; Carvalho, A.; Chaves, M.H.; Cantanhêde, W. Silver and Gold Nanoparticles from Tannic Acid: Synthesis, Characterization and Evaluation of Antileishmanial and Cytotoxic Activities. An. Acad. Bras. Cienc. 2018, 90, 2679–2689. [Google Scholar] [CrossRef]
- Singla, S.; Jana, A.; Thakur, R.; Kumari, C.; Goyal, S.; Pradhan, J. Green synthesis of silver nanoparticles using Oxalis griffithii extract and assessing their antimicrobial activity. OpenNano 2022, 7, 100047. [Google Scholar] [CrossRef]
- Guilger-Casagrande, M.; Germano-Costa, T.; Bilesky-José, N.; Pasquoto-Stigliani, T.; Carvalho, L.; Fraceto, L.F.; de Lima, R. Influence of the capping of biogenic silver nanoparticles on their toxicity and mechanism of action towards Sclerotinia sclerotiorum. J. Nanobiotech. 2021, 19, 53. [Google Scholar] [CrossRef]
- Khane, Y.; Benouis, K.; Albukhaty, S.; Sulaiman, G.M.; Abomughaid, M.M.; Al Ali, A.; Aouf, D.; Fenniche, F.; Khane, S.; Chaibi, W.; et al. Green synthesis of silver nanoparticles using aqueous Citrus limon zest extract: Characterization and evaluation of their antioxidant and antimicrobial properties. Nanomaterials 2022, 12, 2013. [Google Scholar] [CrossRef]
- Khadka, D.; Regmi, R.; Shrestha, M.; Banjara, M.R. Green Synthesis of Silver Nanoparticles using Medicinal Plants Berberis asiatica and Cassia fistula and Evaluation of Antioxidant and Anti-bacterial Activities. Nepal. J. Sci. Technol. 2020, 19, 25–32. [Google Scholar] [CrossRef]
- Devaraj, P.; Kumari, P.; Aarti, C.; Renganathan, A. Synthesis and characterization of silver nanoparticles using cannonball leaves and their cytotoxic activity against MCF-7 cell line. J. Nanotechnol. 2013, 2013, 598328. [Google Scholar] [CrossRef]
- Isaac, R.S.; Sakthivel, G.; Murthy, C.H. Green synthesis of gold and silver nanoparticles using Averrhoa bilimbi fruit extract. J. Nanotechnol. 2013, 2013, 906592. [Google Scholar] [CrossRef]
- Vijayaraghavan, K.; Nalini, S.K.; Prakash, N.U.; Madhankumar, D. One step green synthesis of silver nano/microparticles using extracts of Trachyspermum ammi and Papaver somniferum. Colloids Surf. B 2012, 94, 114–117. [Google Scholar] [CrossRef]
- Kawahara, N.; Tamura, T.; Inoue, M.; Hosoe, T.; Kawai, K.; Sekita, S.; Satake, M.; Goda, Y. Diterpenoid glucosides from Salvia greggii. Phytochemistry 2004, 65, 2577–2581. [Google Scholar] [CrossRef]
- Bayat, M.; Zargar, M.; Chudinova, E.; Astarkhanova, T.; Pakina, E. In Vitro Evaluation of Antibacterial and Antifungal Activity of Biogenic Silver and Copper Nanoparticles: The First Report of Applying Biogenic Nanoparticles against Pilidium concavum and Pestalotia sp. Fungi. Molecules 2021, 26, 5402. [Google Scholar] [CrossRef]
- Renuka, R.R.; Ravindranath, R.R.S.; Raguraman, V.; Yoganandham, S.T.; Kasivelu, G.; Lakshminarayanan, A. In Vivo Toxicity Assessment of Laminarin Based Silver Nanoparticles from Turbinaria ornata in Adult Zebrafish (Danio rerio). J. Clust. Sci. 2019, 31, 185–195. [Google Scholar] [CrossRef]
- Gurunathan, S.; Kalishwaralal, K.; Vaidyanathan, R.; Pandian, S.R.; Muniyandi, J.; Hariharan, N.; Eom, S.H. Biosynthesis, Purification and Characterization of Silver Nanoparticles using Escherichia coli. Colloids Surf. B Biointerfaces 2009, 74, 328–335. [Google Scholar] [CrossRef]
- Khorasani, S.; Yazdi, A.P.G.; Saadatfar, A.; Rousta, L.K.; Nejatian, M.; Abarian, M.; Jafari, S.M. Valorization of Saffron Tepals for the Green Synthesis of Silver Nanoparticles and Evaluation of Their Efficiency Against Foodborne Pathogens. Waste Biomass Valorization 2022, 13, 4417–4430. [Google Scholar] [CrossRef]
- Bhatia, D.; Mittal, A.; Malik, D.K. Antimicrobial Potential and In vitro Cytotoxicity Study of Polyvinyl pyrollidone-stabilized Silver Nanoparticles Synthesised from Lysinibacillus boronitolerans. IET Nanobiotechnology 2021, 15, 427–440. [Google Scholar] [CrossRef] [PubMed]
- Oves, M.; Rauf, A.M.; Aslam, M.; Qari, H.A.; Sonbol, H.; Ahmad, I.; Zaman, G.S.; Saeed, M. Green synthesis of silver nanoparticles by Conocarpus lancifolius plant extract and their antimicrobial and anticancer activities. Saudi. J. Biol. Sci. 2022, 29, 460–471. [Google Scholar] [CrossRef]
- Yassin, M.T.; Mostafa, A.A.-F.; Al-Askar, A.A.; Al-Otibi, F.O. Facile green synthesis of silver nanoparticles using aqueous leaf extract of Origanum majorana with potential bioactivity against multidrug-resistant bacterial strains. Crystals 2022, 12, 603. [Google Scholar] [CrossRef]
- Chahardoli, A.; Mavaei, M.; Shokoohinia, Y.; Fattahi, A. Galbanic acid, a sesquiterpene coumarin as a novel candidate for the biosynthesis of silver nanoparticles: In vitro hemocompatibility, antiproliferative, antibacterial, antioxidant, and anti-inflammatory properties. Adv. Powder Technol. 2023, 34, 103928. [Google Scholar] [CrossRef]
- Nayab, D.; Akhtar, S. Green Synthesized Silver Nanoparticles from Eucalyptus Leaves can Enhance Shelf life of Banana without Penetrating in Pulp. PLoS ONE 2023, 18, e0281675. [Google Scholar] [CrossRef]
- Wu, D.; Fan, W.; Kishen, A. Evaluation of the antibacterial efficacy of silver nanoparticles against Enterococcus faecalis biofilm. J. Endod. 2014, 40, 285–290. [Google Scholar] [CrossRef] [PubMed]
- Kvitek, L.; Panacek, A.; Soukupova, J.; Kolar, M.; Vecerova, R.; Prucek, R.; Holecova, M.; Zboril, R. Effect of surfactants and polymers on stability and antibacterial activity of silver nanoparticles (NPs). J. Phys. Chem. 2008, 112, 5825–5834. [Google Scholar] [CrossRef]
- Sharma, S.; Kumar, K.; Thakur, N. The effect of shape and size of ZnO nanoparticles on their antimicrobial and photocatalytic activities: A green approach. Bull. Matt. Sci. 2020, 43, 20. [Google Scholar] [CrossRef]
- Ghaffar, N.; Javad, S.; Farrukh, M.A.; Shah, A.A.; Gatasheh, M.K.; AL-Munqedhi, B.M.A.; Chaudhry, O. Metal nanoparticles assisted revival of Streptomycin against MDRS Staphylococcus aureus. PLoS ONE 2022, 17, e0264588. [Google Scholar] [CrossRef]
- Lok, C.N.; Ho, C.M.; Chen, R.; He, Q.Y.; Yu, W.Y.; Sun, H.; Tam, P.K.; Chiu, J.F.; Che, C.M. Proteomic Analysis of the Mode of Antibacterial Action of Silver Nanoparticles. J. Proteome Res. 2006, 5, 916–924. [Google Scholar] [CrossRef]
- Sondi, I.; Salopek-Sondi, B. Silver Nanoparticles as Antimicrobial Agent: A Case Study on E. coli as a Model for Gram-Negative Bacteria. J. Colloid Interface Sci. 2004, 275, 177–182. [Google Scholar] [CrossRef]
- Nanda, A.; Saravanan, M. Biosynthesis of Silver Nanoparticles from Staphylococcus aureus and Its Antimicrobial Activity against MRSA and MRSE. Nanomed. Nanotechnol. Biol. Med. 2009, 5, 452–456. [Google Scholar] [CrossRef] [PubMed]
- Rai, M.; Yadav, A.; Gade, A. Silver Nanoparticles as a New Generation of Antimicrobials. Biotechnol. Adv. 2009, 27, 76–83. [Google Scholar] [CrossRef] [PubMed]
- Brennan, S.A.; Fhoghlu, C.N.; Devitt, B.M.; Omahony, F.J.; Brabazon, D.; Walsh, A. Silver nanoparticles and their orthopedic applications. Bone Jt. J. 2015, 97, 582–589. [Google Scholar] [CrossRef] [PubMed]
- Morones-Ramirez, J.R.; Winkler, J.A.; Spina, C.S.; Collins, J.J. Silver Enhances Antibiotic Activity against Gram-Negative Bacteria. Sci. Trans. Med. 2005, 5, 190ra81. [Google Scholar] [CrossRef]
- Pal, S.; Tak, Y.K.; Song, J.M. Does the Antibacterial Activity of Silver Nanoparticles Depend on the Shape of the Nanoparticle? A Study of the Gram-Negative Bacterium Escherichia coli. Appl. Environ. Microbiol. 2007, 73, 1712–1720. [Google Scholar] [CrossRef]
- Salem, S.S.; Fouda, A. Green synthesis of metallic nanoparticles and their prospective biotechnological applications: An overview. Biol. Trace Elem. Res. 2020, 199, 344–370. [Google Scholar] [CrossRef] [PubMed]
- Yamanaka, M.; Hara, K.; Kudo, J. Bactericidal action of silver ion solution on Escherichia Coli, studied by energy-filtering transmission electron microscopy and proteomic analysis. Appl. Environ. Microbiol. 2005, 71, 7589–7593. [Google Scholar] [CrossRef] [PubMed]
- Morones, J.R.; Elechiguerra, J.L.; Camacho, A.; Holt, K.; Kouri, J.B.; Ramirez, J.T.; Yacaman, M.J. The bactericidal effect of silver nanoparticles. Nanotechnology 2005, 16, 2346. [Google Scholar] [CrossRef]
- Li, J.; Rong, K.; Zhao, H.; Li, F.; Lu, Z.; Chen, R. Highly selective antibacterial activities of silver nanoparticles against Bacillus subtilis. J. Nanosci. Nanotechnol. 2013, 13, 6806–6813. [Google Scholar] [CrossRef]
- Jones, M.C.; Hoek, E.M. A review of the antibacterial effects of silver nanomaterials and potential implications for human health and the environment. J. Nanopart. Res. 2010, 12, 1531–1551. [Google Scholar] [CrossRef]
- Vieira, A.J.S.C.; Gaspar, E.M.; Santos, P.M.P. Mechanisms of potential antioxidant activity of caffeine. Radiat. Phys. Chem. 2020, 174, 1089. [Google Scholar] [CrossRef]
- Hailan, W.A.; Al-Anazi, K.M.; Farah, M.A.; Ali, M.A.; Al-Kawmani, A.A.; Abou-Tarboush, F.M. Reactive oxygen species-mediated cytotoxicity in liver carcinoma cells induced by silver nanoparticles biosynthesized using Schinus molle extract. Nanomaterials 2022, 12, 161. [Google Scholar] [CrossRef] [PubMed]
- Shankar, E.M.; Mohan, V.; Premalatha, G.; Srinivasan, R.S.; Usha, A.R. Bacterial etiology of diabetic foot infections in South India. Eur. J. Intern. Med. 2005, 16, 567–570. [Google Scholar] [CrossRef] [PubMed]
- Hussain, Z.; Yusoff, Z.M.; Sulaiman, S.A.S. Evaluation of knowledge regarding gestational diabetes mellitus and its association with glycaemic level: A Malaysian study. Prim. Care Diabetes 2015, 9, 184–190. [Google Scholar] [CrossRef] [PubMed]
- Zubair, M.; Azeem, M.; Mumtaz, R.; Younas, M.; Adrees, M.; Zubair, E.; Khalid, A.; Hafeez, F.; Rizwan, M.; Ali, S. Green synthesis and characterization of silver nanoparticles from Acacia nilotica and their anticancer, antidiabetic and antioxidant efficacy. Environ. Pollut. 2022, 304, 119249. [Google Scholar] [CrossRef] [PubMed]
- AshaRani, P.V.; Hande, M.P.; Valiyaveettil, S. Anti-proliferative activity of silver nanoparticles. BMC Cell Biol. 2012, 13, 14. [Google Scholar] [CrossRef]
- Samuni, A.; Maimon, E.; Goldstein, S.; Sharma, R. Inhibition of hydroxyl radical and hydroxyl radical-induced lipid peroxidation by a chelating complex of copper and N-acetylcysteine. Free Radic. Biol. Med. 2013, 55, 3–11. [Google Scholar]
- Kim, T.H.; Kim, M.; Park, H.S. Size-dependent cellular toxicity of silver nanoparticles. J. Biomed. Mater. Res. A 2009, 90, 822–829. [Google Scholar] [CrossRef]
- AshaRani, P.V.; Mun, G.L.K.; Hande, M.P.; Valiyaveettil, S. Cytotoxicity and genotoxicity of silver nanoparticles in human cells. ACS Nano 2014, 3, 279–290. [Google Scholar] [CrossRef]
- Park, E.J.; Yi, J.; Kim, Y.; Choi, K.; Park, K. Silver Nanoparticles induce cytotoxicity by a Trojan-horse type mechanism. Toxicology Vitr. 2011, 25, 690–696. [Google Scholar] [CrossRef]
- Goodman, G.; Hardman, J.; Limbird, L.; Goodman, G.A. Insulin, oral hypoglycaemic agents and the pharmacology of endocrine pancreas. Pharmacol. Basis Ther. 2006, 60, 1686–1710. [Google Scholar]
- Malapermal, V.; Botha, I.; Krishna, S.B.N.; Mbatha, J.N. Enhancing antidiabetic and antimicrobial performance of Ocimum basilicum, and Ocimum sanctum (L.) using silver nanoparticles. Saudi J. Biol. Sci. 2017, 24, 1294–1305. [Google Scholar] [CrossRef]
- Jamdade, D.A.; Rajpali, D.; Joshi, K.A.; Kitture, R.; Kulkarni, A.S.; Shinde, V.S.; Bellare, J.; Babiya, K.R.; Ghosh, S. Gnidia glauca- and Plumbago zeylanica- mediated synthesis of novel copper nanoparticles as promising antidiabetic agents. Adv. Pharmacol. Sci. 2019, 2019, 9080279. [Google Scholar] [CrossRef] [PubMed]
- Avwioroko, O.J.; Oyetunde, T.T.; Atanu, F.O.; Otuechere, C.A.; Anigboro, A.A.; Dairo, O.F.; Ejoh, A.S.; Ajibade, S.O.; Omorogie, M.O. Exploring the binding interactions of structurally diverse dichalcogenoimidodiphosphinate ligands with α-amylase: Spectroscopic approach coupled with molecular docking. Biochem. Biophys. Rep. 2020, 24, 100837. [Google Scholar] [CrossRef] [PubMed]
- Vinodhini, S.; Vithiya, B.S.M.; Prasad, T.A.A. Green synthesis of palladium nanoparticles using aqueous plant extracts and its biomedical applications. J. King Saud. Univ. Sci. 2022, 34, 102017. [Google Scholar] [CrossRef]
- Kumar, O.; Singh, S.; Srivastava, B.; Bhadouria, R.; Singh, R. Green synthesis of silver nanoparticles using leaf extract of Holoptelea integrifolia and preliminary investigation of its antioxidant, anti-inflammatory, antidiabetic and antibacterial activities. J. Environ. Chem. Eng. 2019, 7, 103094. [Google Scholar] [CrossRef]
- Govindappa, M.; Hemashekhar, B.; Arthikala, M.K.; Rai, V.R.; Ramachandra, Y.L. Characterization, antibacterial, antioxidant, antidiabetic, anti-inflammatory and antityrosinase activity of green synthesized silver nanoparticles using Calophyllum tomentosum leaves extract. Results Phys. 2018, 9, 400–408. [Google Scholar] [CrossRef]
- Saratale, R.G.; Shin, H.S.; Kumar, G.; Benelli, G.; Kim, D.S.; Saratale, G.D. Exploiting antidiabetic activity of silver nanoparticles synthesized using Punica granatum leaves and anticancer potential against human liver cancer cells (HepG2). Artif. Cells Nanomed. Biotechnol. 2018, 46, 211–222. [Google Scholar] [CrossRef] [PubMed]
- Saratale, G.D.; Saratale, R.G.; Kim, D.S.; Kim, D.Y.; Shin, H.S. Exploiting fruit waste grape pomace for silver nanoparticles synthesis, assessing their antioxidant, antidiabetic potential and antibacterial activity against human pathogens: A novel approach. Nanomaterials 2020, 10, 1457. [Google Scholar] [CrossRef]
- Das, G.; Patra, J.K.; Debnath, T.; Ansari, A.; Shin, H.S. Investigation of antioxidant, antibacterial, antidiabetic, and cytotoxicity potential of silver nanoparticles synthesized using the outer peel extract of Ananas comosus (L.). PLoS ONE 2019, 14, e0220950. [Google Scholar] [CrossRef]
- Bashan, N.; Kovsan, J.; Kachko, I.; Ovadia, H.; Rudich, A. Positive and negative regulation of insulin signaling by reactive oxygen and nitrogen species. Physiol Rev. 2009, 89, 27–71. [Google Scholar] [CrossRef] [PubMed]
- Williamson, G. Possible effects of dietary polyphenols on sugar absorption and digestion. Mol. Nutr. Food Res. 2013, 57, 48–57. [Google Scholar] [CrossRef] [PubMed]
- Pitocco, D.; Tesauro, M.; Alessandro, R.; Ghirlanda, G.; Cardillo, C. Oxidative Stress in Diabetes: Implications for Vascular and Other Complications. Int. J. Mol. Sci. 2013, 14, 21525–21550. [Google Scholar] [CrossRef] [PubMed]
- Wikler, M.A. Methods for Dilution Antimicrobial Susceptibility Tests for Bacteria That Grow Aerobically: Approved Standard; Clinical and Laboratory Standards Institute: Wayne, PA, USA, 2006. [Google Scholar]
- Sathiyaseelan, A.; Saravanakumar, K.; Mariadoss, A.V.A.; Wang, M.H. Biocompatible Fungal Chitosan Encapsulated Phytogenic Silver Nanoparticles Enhanced Antidiabetic, Antioxidant and Antibacterial Activity. Int. J. Biol. Macromol. 2020, 153, 63–71. [Google Scholar] [CrossRef]

| Bacteria | Streptomycin | SBLE | SB-AgNPs | SGLE | SG-AgNPs | ||||
|---|---|---|---|---|---|---|---|---|---|
| 100 | 75 | 50 | 100 | 75 | 50 | ||||
| E. coli | 16 ± 1.8 ab | 11.2 ± 1.1 b | 14 ± 1.3 bc | 13 ± 1.3 bc | 13 ± 1.2 bc | 11.3 ± 1.1 b | 16 ± 1.4 ab | 15 ± 1.7 ab | 12 ± 1.2 b |
| S. typhimurium | 11 ± 1.5 b | 6.5 ± 0.7 c | 11 ± 1.1 b | 10 ± 1.0 b | 9 ± 0.9 bc | 6.3 ± 0.7 c | 12 ± 0.9 b | 9 ± 0.8 bc | 7 ± 0.6 c |
| S. aureus | 18 ± 1.7 a | 6.2 ± 0.6 c | 16.3 ± 1.5 ab | 15 ± 1.2 b | 14 ± 1.2 ab | 6.4 ± 0.5 c | 17.6 ± 1.7 a | 16 ± 1.3 ab | 15 ± 1.5 ab |
| L. monocytogenes | 20 ± 1.8 a | 6.2 ± 0.7 c | 19.2 ± 1.5 a | 16 ± 1.4 ab | 15 ± 1.4 ab | 6.5 ± 0.6 c | 20.5 ± 1.8 a | 17 ± 1.5 ab | 15 ± 0.9 ab |
| Bacteria | SB-AgNPs (μg mL−1) | SG-AgNPs (μg mL−1) | ||
|---|---|---|---|---|
| MIC | MBC | MIC | MBC | |
| E. coli | 39 ± 4.1 ab | 83 ± 6.1 b | 40 ± 4.1 b | 78.5 ± 5.4 b |
| S. typhimurium | 45.2 ± 5.3 a | 98 ± 5.1 a | 53 ± 3.6 a | 88.5 ± 7.2 a |
| S. aureus | 32.4 ± 2.5 b | 54 ± 3.6 c | 30 ± 3.2 c | 50.2 ± 4.2 c |
| L. monocytogenes | 25.7 ± 3.2 c | 45 ± 3.2 d | 23.5 ± 2.5 d | 42.7 ± 3.1 d |
Disclaimer/Publisher’s Note: The statements, opinions and data contained in all publications are solely those of the individual author(s) and contributor(s) and not of MDPI and/or the editor(s). MDPI and/or the editor(s) disclaim responsibility for any injury to people or property resulting from any ideas, methods, instructions or products referred to in the content. |
© 2024 by the authors. Licensee MDPI, Basel, Switzerland. This article is an open access article distributed under the terms and conditions of the Creative Commons Attribution (CC BY) license (https://creativecommons.org/licenses/by/4.0/).
Share and Cite
Geremew, A.; Gonzalles, J., III; Peace, E.; Woldesenbet, S.; Reeves, S.; Brooks, N., Jr.; Carson, L. Green Synthesis of Novel Silver Nanoparticles Using Salvia blepharophylla and Salvia greggii: Antioxidant and Antidiabetic Potential and Effect on Foodborne Bacterial Pathogens. Int. J. Mol. Sci. 2024, 25, 904. https://doi.org/10.3390/ijms25020904
Geremew A, Gonzalles J III, Peace E, Woldesenbet S, Reeves S, Brooks N Jr., Carson L. Green Synthesis of Novel Silver Nanoparticles Using Salvia blepharophylla and Salvia greggii: Antioxidant and Antidiabetic Potential and Effect on Foodborne Bacterial Pathogens. International Journal of Molecular Sciences. 2024; 25(2):904. https://doi.org/10.3390/ijms25020904
Chicago/Turabian StyleGeremew, Addisie, John Gonzalles, III, Elisha Peace, Selamawit Woldesenbet, Sheena Reeves, Nigel Brooks, Jr., and Laura Carson. 2024. "Green Synthesis of Novel Silver Nanoparticles Using Salvia blepharophylla and Salvia greggii: Antioxidant and Antidiabetic Potential and Effect on Foodborne Bacterial Pathogens" International Journal of Molecular Sciences 25, no. 2: 904. https://doi.org/10.3390/ijms25020904
APA StyleGeremew, A., Gonzalles, J., III, Peace, E., Woldesenbet, S., Reeves, S., Brooks, N., Jr., & Carson, L. (2024). Green Synthesis of Novel Silver Nanoparticles Using Salvia blepharophylla and Salvia greggii: Antioxidant and Antidiabetic Potential and Effect on Foodborne Bacterial Pathogens. International Journal of Molecular Sciences, 25(2), 904. https://doi.org/10.3390/ijms25020904






